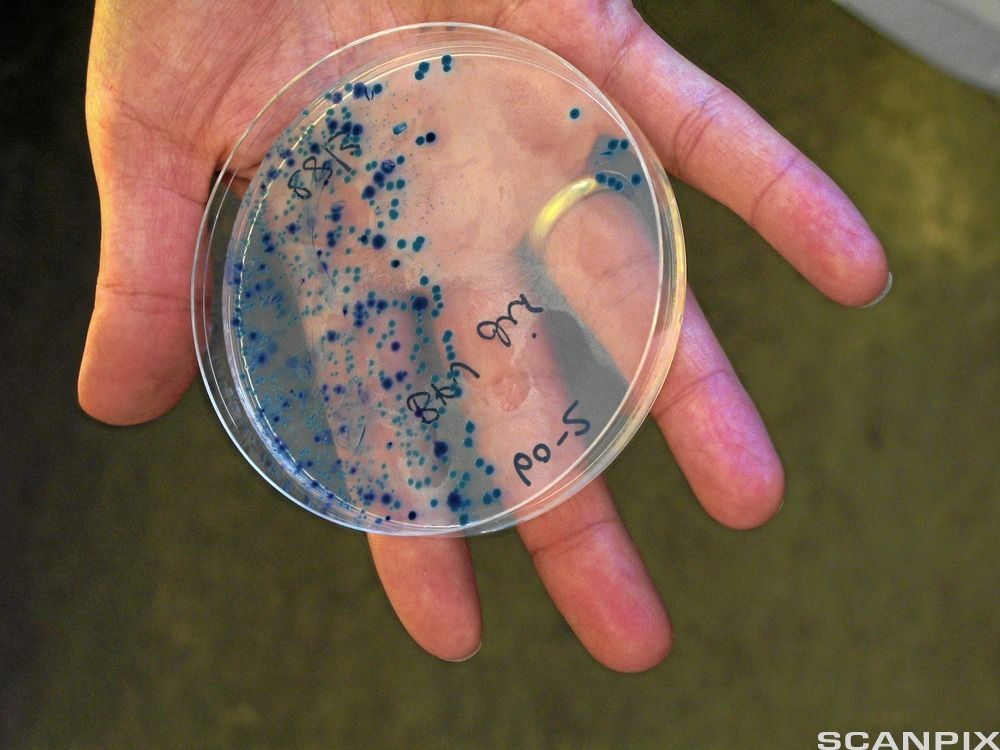
Ei låg, rund skål med ei mengde svarte prikkar på botnen av skåla. Foto.

Medisinbruk og resistens
Resistens
Resistens kjem frå latin og tyder "stå imot". Ein bakterie som er antibiotikaresistent, er ein bakterie som antibiotika ikkje verkar mot. Medisinen har slutta å verke.
Resistens er miljøtilpassing

Når bakteriar blir utsette for rett type antibiotika, døyr dei fleste av dei. Men nokre få har kanskje gen som gjer at dei ikkje døyr av medikamentet. Dei som overlever, vil no formeire seg kraftig, for alle konkurrentane er døde. Etter ei stund har vi mange bakteriar som er resistente. Medisinen verkar ikkje lenger.
Det er ikkje berre bakteriar som kan bli resistente mot behandling. Lakselusa kan òg bli resistent mot dei metodane vi nyttar for å kvitte oss med ho.
Avgrense medisinbruken
For å passe på at den behandlinga vi gir dyra, skal fortsette å verke, er det viktig at vi ikkje behandlar dyr som eigentleg ikkje treng det. Det er òg viktig å behandle dyra på rett tidspunkt og ikkje nytte same behandling fleire gonger på rad.
Det beste er å unngå at dyra blir sjuke i utgangspunktet! Dette kan vi sørge for gjennom førebyggande helsearbeid og gode biosikkerheitstiltak.
Hugselappen
Resistens tyder "stå imot".
Mikroorganismar, parasittar og skadedyr blir resistente mot medisinane vi nyttar.
Unngå sjukdom gjennom godt stell og god hygiene.
Avgrens medisinbruken.